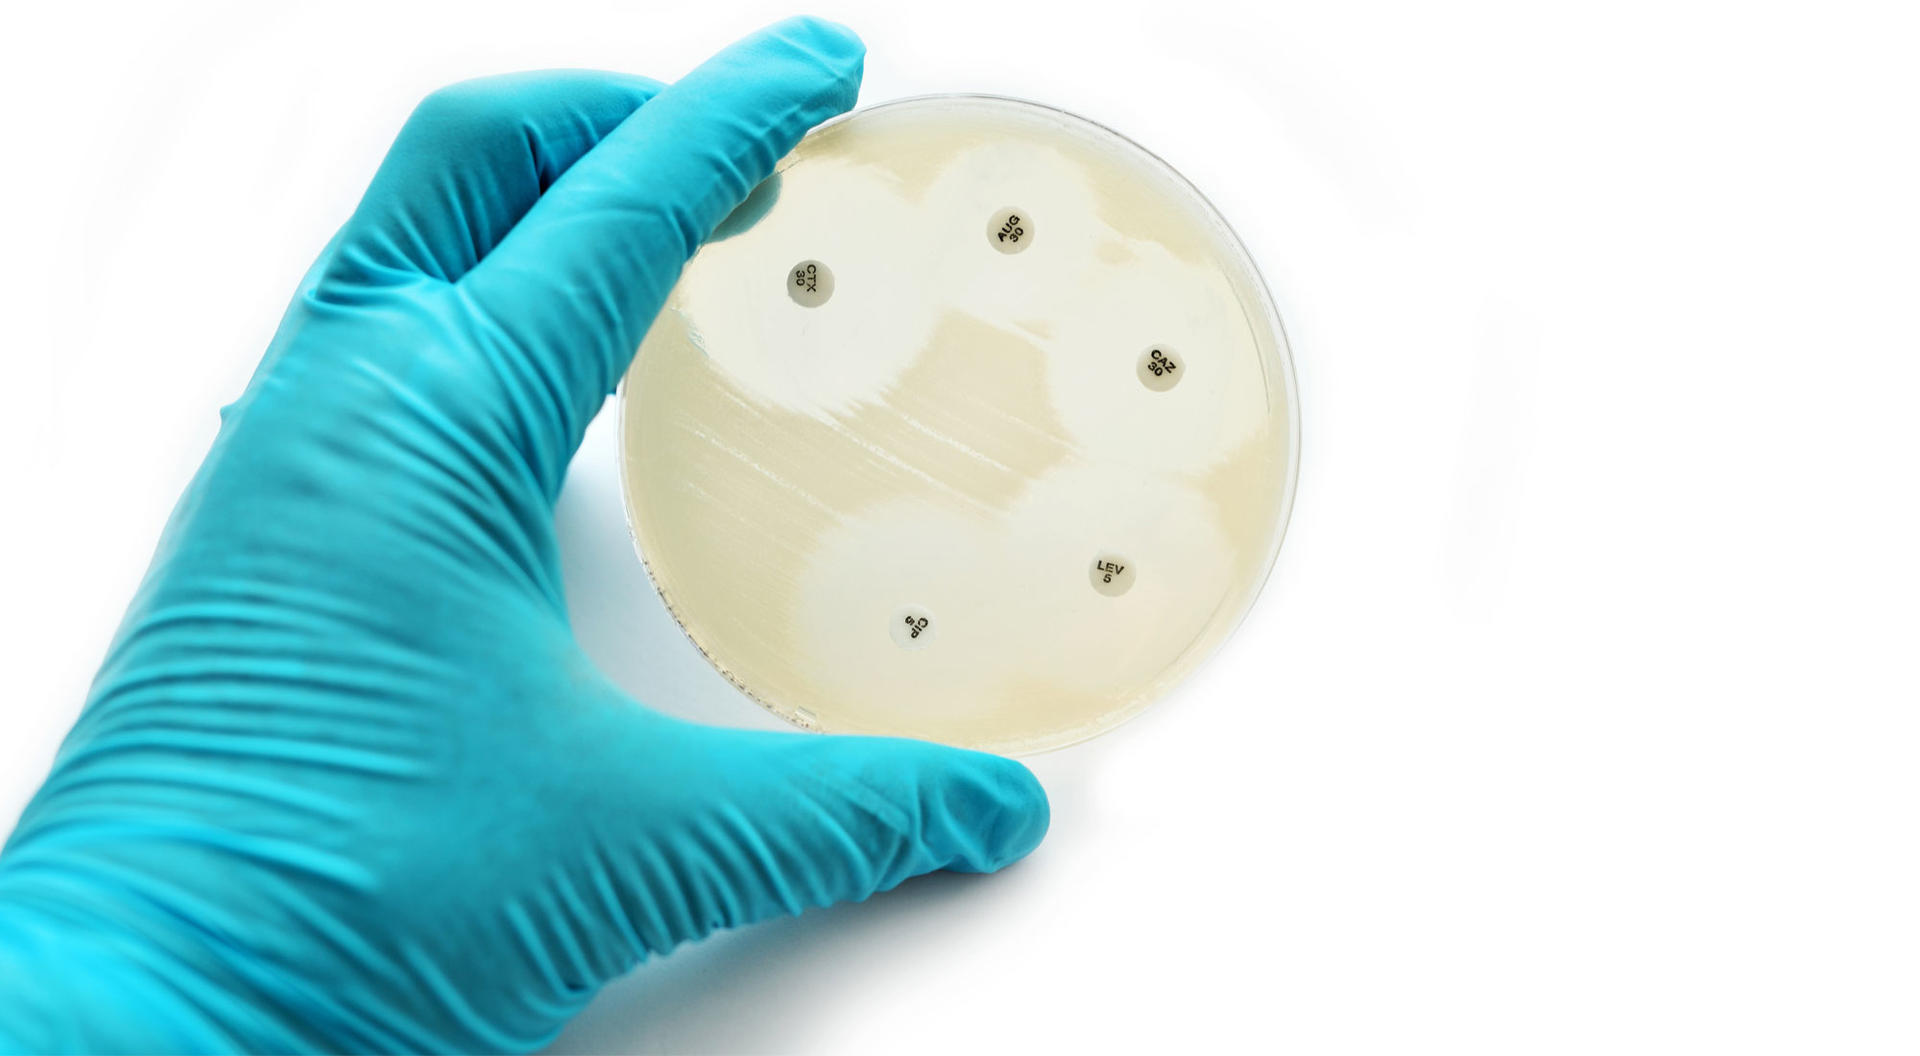

The Reports and Insights, a leading market research company, has recently releases report titled “Antimicrobial Susceptibility Testing Market: Global Industry Trends, Share, Size, Growth, Opportunity and Forecast 2025-2033.” The study provides a detailed analysis of the industry, the report also includes competitor and regional analysis and highlights the latest advancements in the market. The Antimicrobial Susceptibility Testing Market Size was valued at US$ 4.1 Billion in 2024 and is expected to register a CAGR of 5.9% over the forecast period and reach US$ 6.9 Billion in 2033.
Antimicrobial Susceptibility Testing Market Overview
With the rising infectious diseases and growing concern around antimicrobial resistance, the global antimicrobial susceptibility testing (AST) market is likely to rise steadily in the future. AST is commonly used to determine the suitability of antibiotics to pathogens so that clinicians can make a decision. The growing demand for fast and accurate diagnostic methods to effectively manage infections is aiding market growth. In addition, antimicrobial susceptibility testing systems are being used in hospitals, diagnostic laboratories, and research institutions because of the thrust from global health initiatives by organizations like the WHO, CDC, and MDR surveillance.
The antimicrobial susceptibility testing market is made up of automated systems, manual testing kits, reagents, and consumables, among others. Hospitals, diagnostic laboratories, research centres, and pharmaceutical companies are all end-users of it. Different technologies are witnessing adoption in the market, which include automated or molecular type testing technologies that help provide rapid product turnaround time with accuracy. The North American market will hold a major share of the antimicrobial susceptibility testing market by region. This is due to the presence of an advanced healthcare infrastructure in the region. Moreover, there is a strong government backing to support programs such as antimicrobial stewardship programs. On the other hand, the Asia-Pacific region will show a fast growth rate in the antimicrobial susceptibility testing market owing to the increasing number of infections. Furthermore, the massive investment in laboratory capacities in countries like India and China will bolster market growth.
Request for a sample copy with detail analysis: https://www.reportsandinsights.com/sample-request/2306
Antimicrobial Susceptibility Testing Market Growth Factors & Challenges
The rising level of hospital-acquired infection (HAI), combined with a growing worldwide burden of antibiotic resistance, is expected to drive market growth. Moreover, more and more people are now aware of the proper use of antimicrobials. New automated platforms, microfluidics, and next-gen sequencing are changing AST technologies á According to a recent publication. Government initiatives that promote antimicrobial monitoring programs, as well as financing for research on diagnostic innovations, also guarantee the market. As pharmaceutical R&D of new antibiotics expands, it increases demand for AST during preclinical and clinical testing.
The AST market is growing; nevertheless, it has various restraints, like high pricing of automated instruments and a lack of access to advanced testing apparatus in low-resource settings. Having fewer trained laboratory experts and some testing methods taking a long time can delay diagnosis and treatment. On top of that, other barriers include the slow regulatory approval of new AST technologies and the absence of standardized testing guidelines across regions. Clinicians who are used to thinking in terms of empirical antibiotic usage discourage implementation.
Key suggestions for the report
- The automated AST systems segment, by product type, is expected to dominate the market share during the forecast period. Because of the increase in demand for automation in the laboratories of clinical microbiology, for the improvement of efficiency of testing.
- By method type, the molecular testing segment is expected to hold the largest market share because of the increase in the adoption of molecular techniques for the rapid and accurate detection of antimicrobial resistance genes.
- The clinical diagnostic segment by application type is expected to hold the largest revenue share due to the rise in infectious diseases globally, which has increased the demand for the timely diagnosis of microbial infections that is accurate.
- By end user, he hospital and clinics segment is expected to dominate the market share as the volume of samples of patients that are processed in the laboratories of hospitals is higher, and also the focus on infectious control measures has increased.
- By region, North America will hold the largest market share because of the significant investment in R&D, and the advancement of the healthcare infrastructure accounted by the US.
- The report presents information related to key drivers, restraints, and opportunities along with a detailed analysis of the Antimicrobial Susceptibility Testing market share.
Key Trends in Antimicrobial Susceptibility Testing Industry
Various factors are shaping the antimicrobial susceptibility testing market. One trend that is gaining importance is the use of artificial intelligence and data analytics for predictive resistance profiling. Changes in the hospital and production environment can lead to an upsurge of organ damage caused by sepsis. A lot of work is also put towards ultimately achieving personalized anti-microbial therapy, whereby results will help in guiding the choice of antibiotic for a patient. Ties between diagnostics companies like bioMérieux and the Global Antimicrobial Resistance and Use Surveillance System (GLASS) are becoming more common. In addition, the market has witnessed the introduction of nanotechnology-based and molecular AST platforms that are likely to provide greater accuracy, faster testing, and wider access.
Antimicrobial Susceptibility Testing Market Key Applications & Industry Segments
The antimicrobial susceptibility testing market is segmented by product, age group, end-user, and region.
By Product Type
- Automated AST Systems
- Manual AST Products
- Consumables
- Antibiotic Discs
- Plates
- Broth
- Accessories
- Inoculating Loops
- Spreaders
- Services and Software
By Method
- Disk Diffusion
- Broth Dilution
- E-test
- Molecular Testing
- Polymerase Chain Reaction (PCR)
- Sequencing
By Application
- Clinical Diagnostics
- Drug Development and Research
- Epidemiology and Surveillance
- Veterinary Diagnostics
By End User
- Hospitals and Clinics
- Diagnostic Laboratories
- Pharmaceutical and Biotechnology Companies
- Research Institutes and Academic Centers
By Region
- North America (US and Canada)
- Latin America (Brazil, Mexico, Argentina, & Rest of LATM)
- Europe (Germany, United Kingdom, France, Italy, Spain, Russia, Poland, Benelux, Nordic, & Rest of Europe)
- Asia Pacific (China, Japan, India, South Korea, ASEAN, Australia & New Zealand, & Rest of Asia Pacific)
- Middle East & Africa (Saudi Arabia, South Africa, United Arab Emirates, Israel, & Rest of MEA)
View Full Report: https://www.reportsandinsights.com/report/antimicrobial-susceptibility-testing-market
Leading Key Players in the Antimicrobial Susceptibility Testing Market
Some of the key players that are included in the Antimicrobial Susceptibility Testing market report are:
- BD (Becton, Dickinson and Company)
- Synbiosis
- Zhuhai DL Biotech Co., Ltd
- Mast Group Ltd.
- HiMedia Laboratories
- Thermo Fisher Scientific Inc.
- Bio-Rad Laboratories, Inc.
- Creative Diagnostics
- Genefluidics, Inc.
- Rosco Diagnostica A/S
- ERBA Group
- Liofilchem S.r.l.
- Alifax S.r.l.
- MERLIN Gesellschaft für mikrobiologische Diagnostika mbH
- bioMérieux SA
Key Attributes
| Report Attributes | Details |
| No. of Pages | 243 |
| Market Forecast | 2025-2033 |
| Market Value (USD) in 2024 | 4.1 billion |
| Market Value (USD) in 2033 | 6.9 billion |
| Compound Annual Growth Rate (%) | 5.9% |
| Regions Covered | Global |
If you require any specific information that is not covered currently within the scope of the report, we will provide the same as a part of the customization.
About Us:
Reports and Insights consistently mееt international benchmarks in the market research industry and maintain a kееn focus on providing only the highest quality of reports and analysis outlooks across markets, industries, domains, sectors, and verticals. We have bееn catering to varying market nееds and do not compromise on quality and research efforts in our objective to deliver only the very best to our clients globally.
Our offerings include comprehensive market intelligence in the form of research reports, production cost reports, feasibility studies, and consulting services. Our team, which includes experienced researchers and analysts from various industries, is dedicated to providing high-quality data and insights to our clientele, ranging from small and medium businesses to Fortune 1000 corporations.
Contact Us:
Reports and Insights Business Research Pvt. Ltd.
1820 Avenue M, Brooklyn, NY, 11230, United States
Contact No: +1-(347)-748-1518
Email: sales@reportsandinsights.com
Website: https://www.reportsandinsights.com/
Follow us on LinkedIn: https://www.linkedin.com/company/report-and-insights/
Follow us on twitter: https://twitter.com/ReportsandInsi1
Leave a Reply